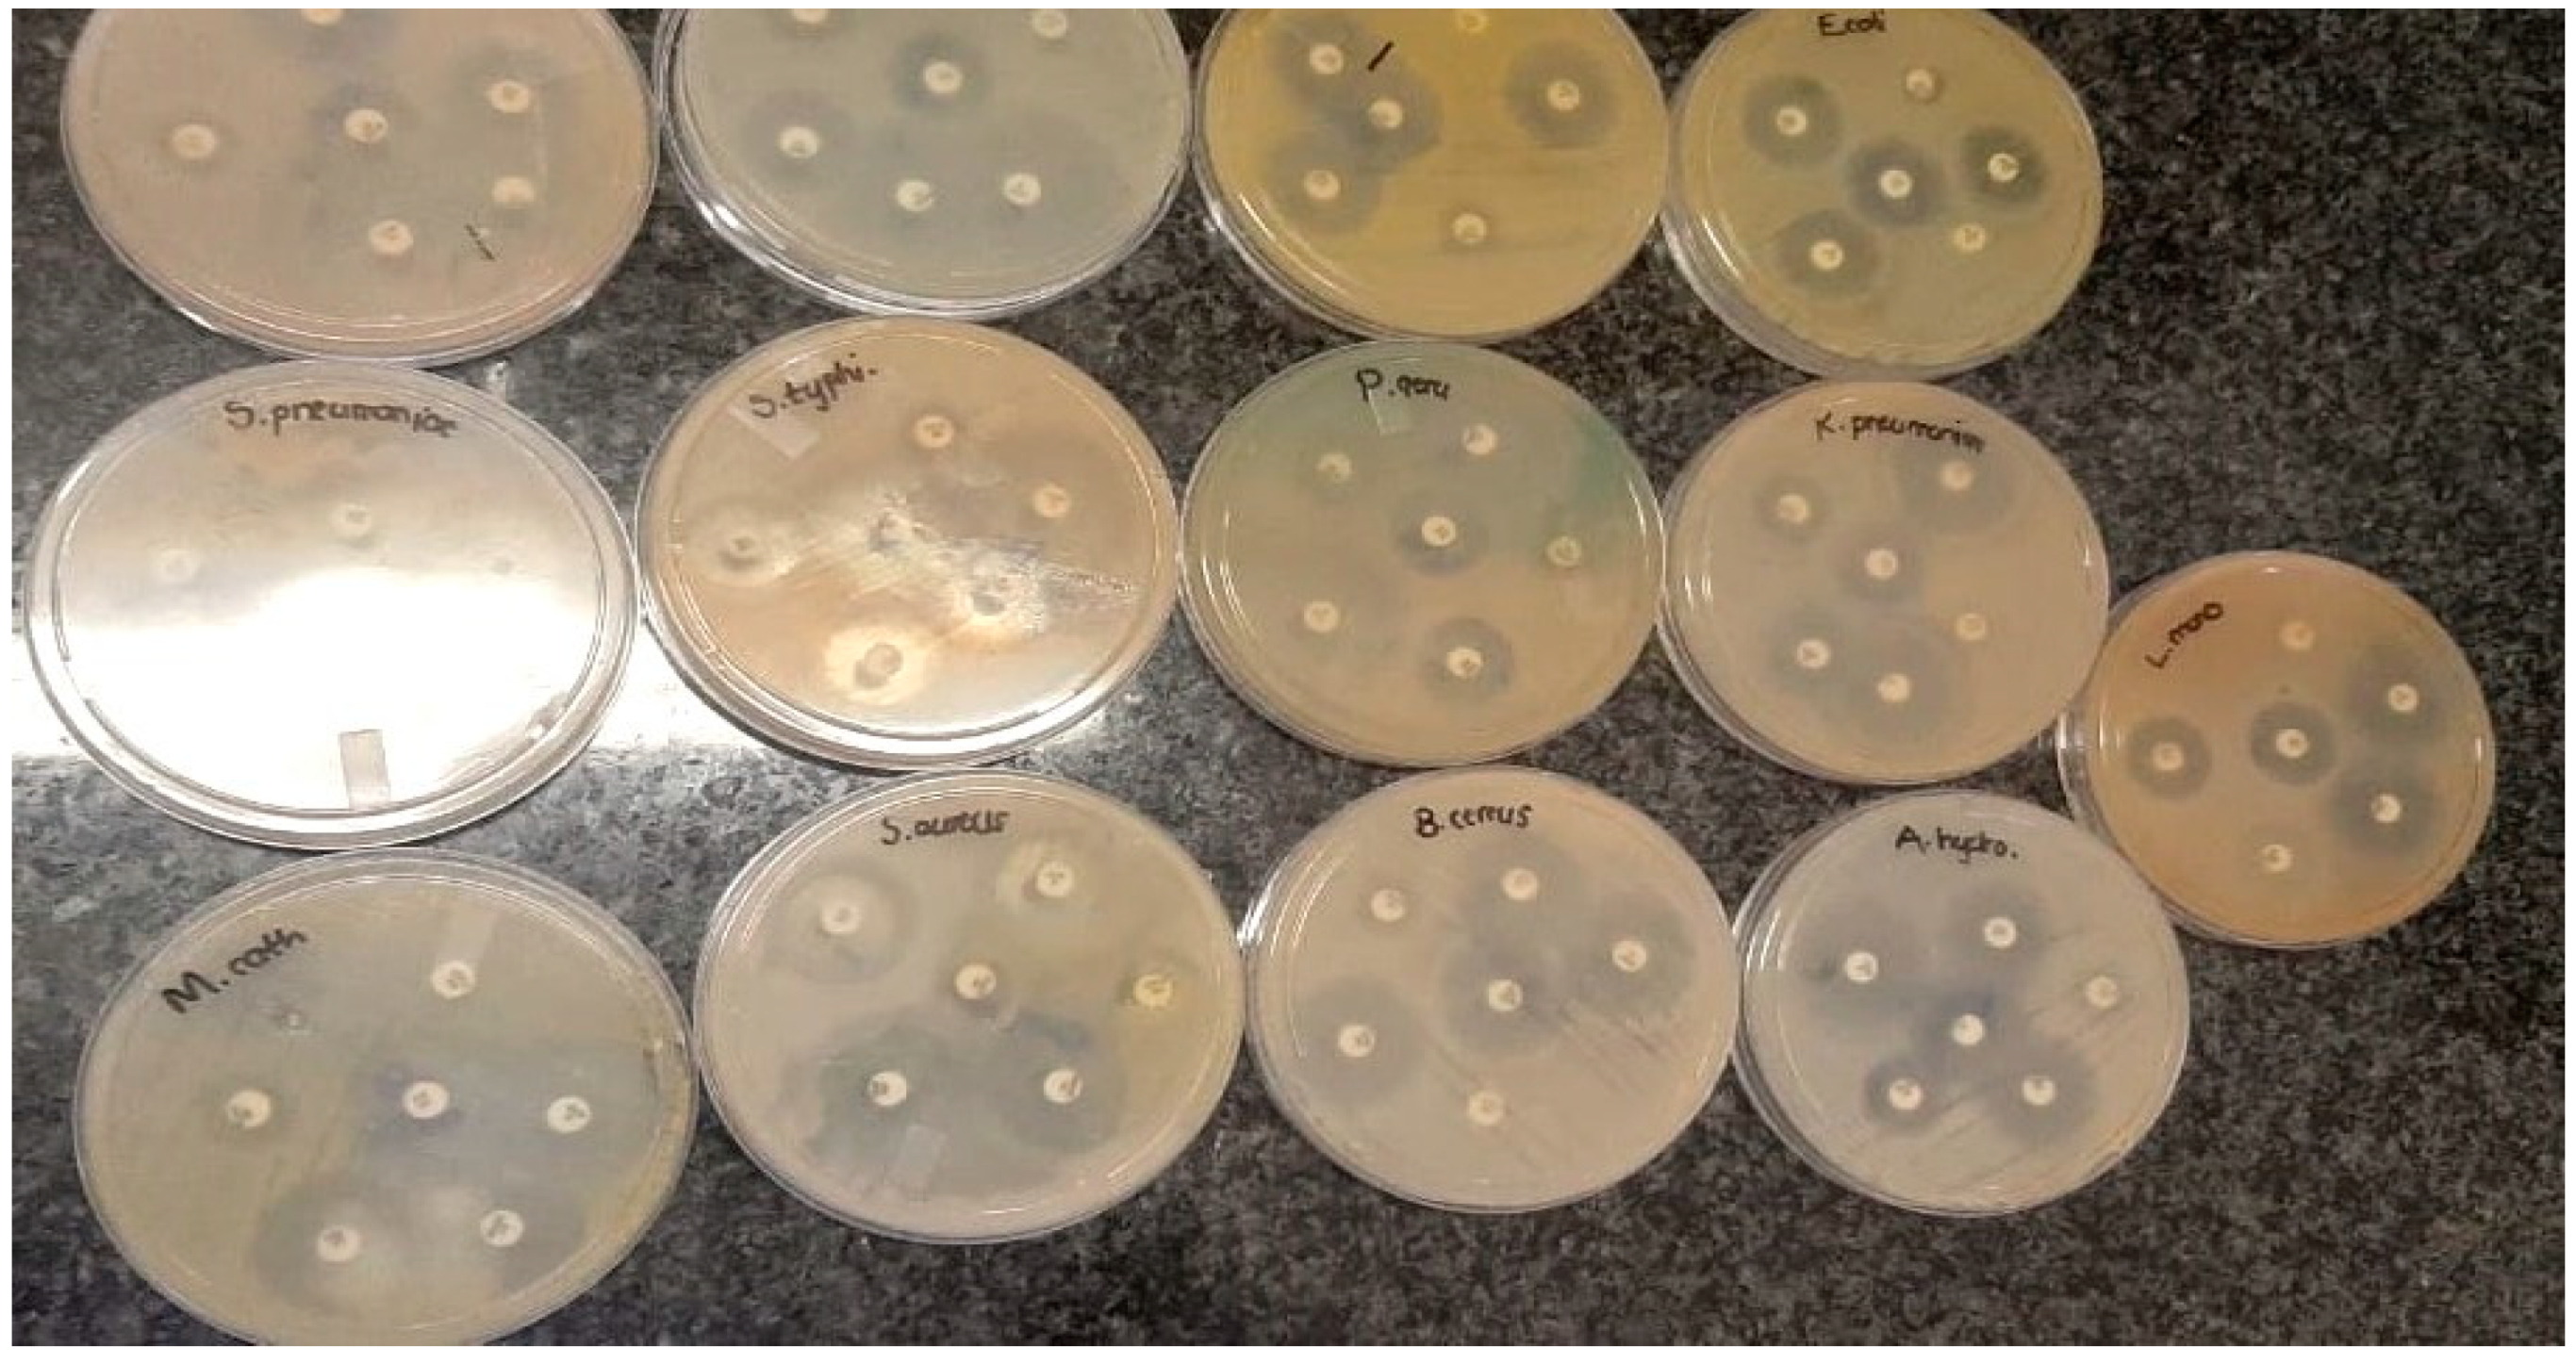
Molecules 25 04521 g010
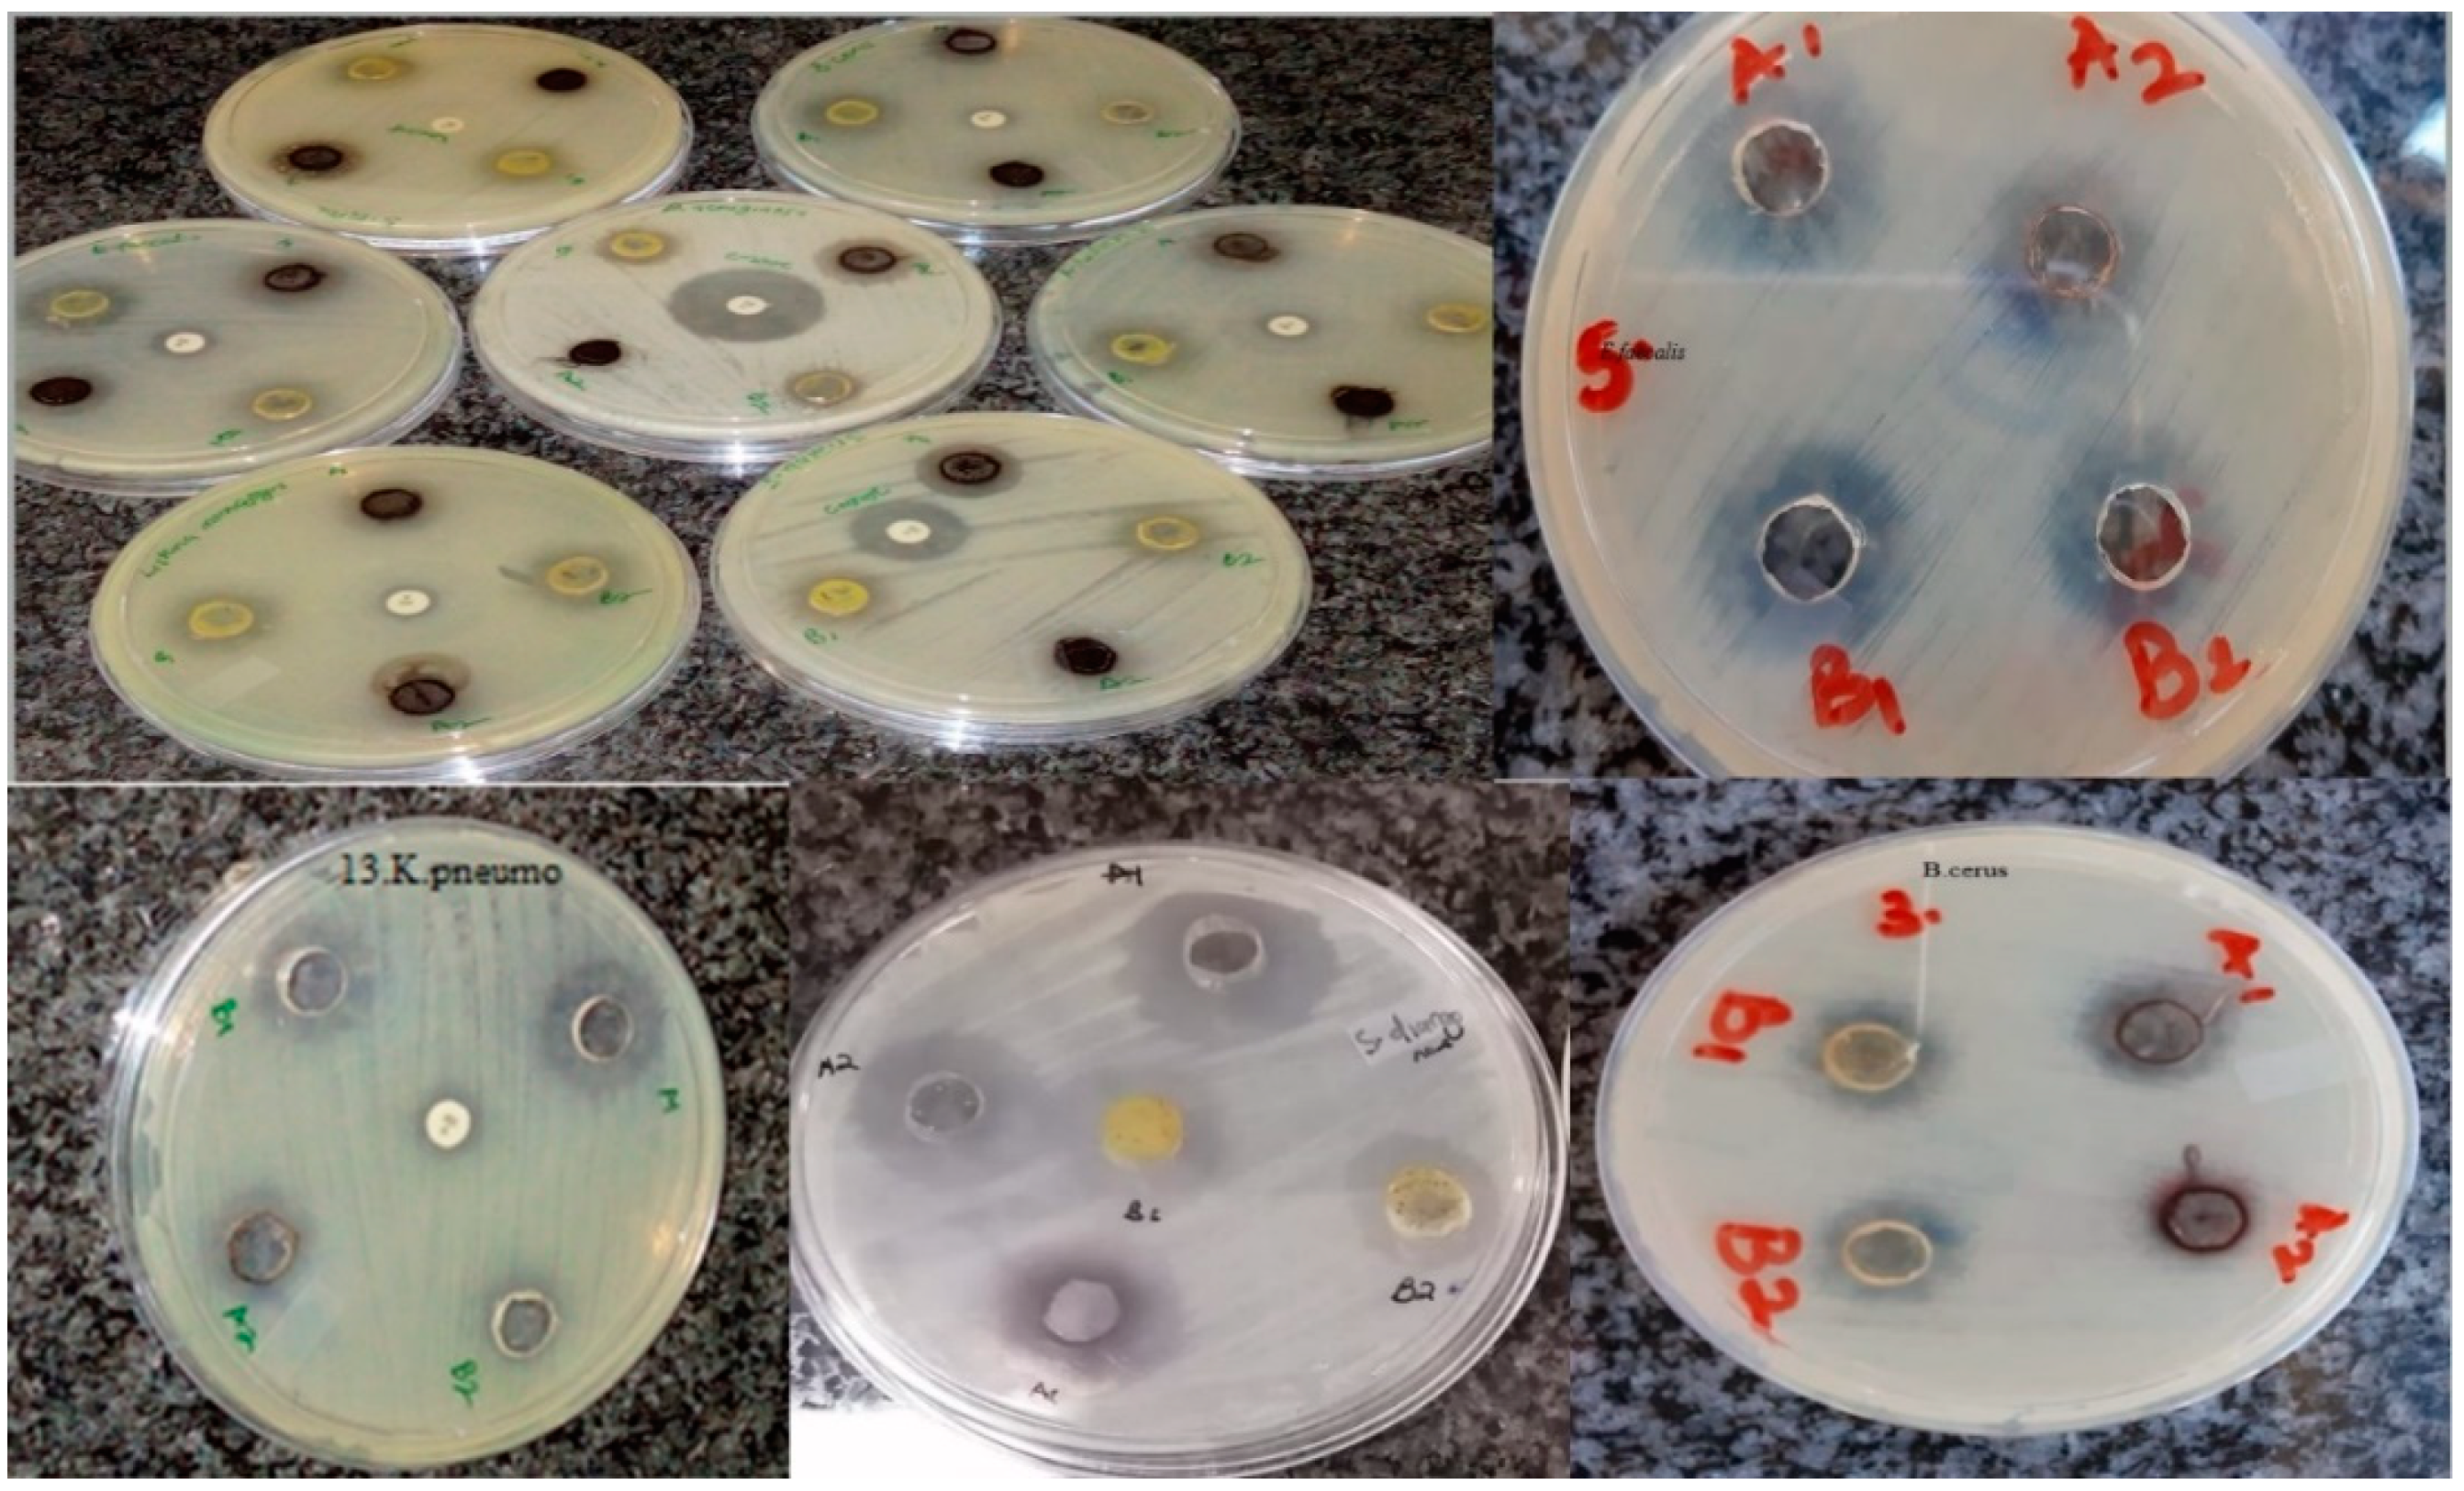
Molecules 25 04521 g011

Green Synthesis of Zinc Oxide Nanoparticles from Pomegranate (Punica granatum) Extracts and Characterization of Their Antibacterial Activity
Abstract
1. Introduction
2. Materials and Methods
2.1. Collection and Preparation of Pomegranate Leaf and Flower Extract
2.2. Synthesis of Zinc Oxide Nanoparticles
2.3. Characterization of the Synthesized Metal Oxide Nanoparticles
2.4. Preparation of Nanoparticle Suspensions
2.5. Antimicrobial Activity of the Synthesized Metal Oxide Nanoparticles
2.6. Preparation of Bacterial Inocula
2.7. Antibiogram Test of Bacterial Strains
2.8. Antibacterial Activity of Biosynthesized Zinc Oxide Nanoparticles
2.9. Determination of Minimum Inhibitory Concentration (MIC) of the Synthesized Zinc Oxide Nanoparticles
2.10. Time–Kill Kinetics Assay
2.11. Statistical Analysis
3. Results
3.1. Transmission Electron Microscopy
3.2. Ultraviolet–Visible (UV–Vis) Spectroscopy
3.3. Fourier Transform Infrared Spectroscopy (FTIR)
3.4. X-ray Diffraction (XRD) Analysis
- k = 0.89 (shape factor)
- λ = X-ray wavelength (1.5406 A°)
- β denotes full width at half maximum (FWHM) in radians
- Ɵ denotes the Bragg diffraction angle.
3.5. Scanning Electron Microscopy with Energy Dispersive X-ray (EDX)
3.6. Antibacterial Activity
3.7. Antibacterial Activity of Synthesized Metal Oxides Nanoparticles
3.8. Determination of Minimum Inhibitory Concentrations (MICs) of the Synthesized Metal Oxide Nanoparticles
3.9. Killing Time
4. Conclusions
Author Contributions
Funding
Acknowledgments
Conflicts of Interest
References
- Gold, K.; Slay, B.; Knackstedt, M.; Gaharwar, A.K. Antimicrobial activity of metal and metal-oxide based nanoparticles. Adv. Ther. 2018, 1, 1700033. [Google Scholar] [CrossRef]
- Wang, L.; Hu, C.; Shao, L. The antimicrobial activity of nanoparticles: Present situation and prospects for the future. Int. J. Nanomed. 2017, 12, 1227–1249. [Google Scholar] [CrossRef] [PubMed]
- Singh, P.; Garg, A.; Pandit, S.; Mokkapati, V.R.; Mijakovic, I. Antimicrobial effects of biogenic nanoparticles. Nanomaterials 2018, 8, 1009. [Google Scholar] [CrossRef] [PubMed]
- Jones, N.; Ray, B.; Ranjit, K.T.; Manna, A.C. Antibacterial activity of zinc oxide nanoparticle suspensions on a broad spectrum of microorganisms. FEMS Microbiol. Lett. 2008, 279, 71–76. [Google Scholar] [CrossRef]
- Vega-Jiménez, A.L.; Vázquez-Olmos, A.R.; Acosta-Gío, E.; Álvarez-Pérez, M.A. In-vitro antimicrobial activity evaluation of metal oxide nanoparticles. In Nanoemulsions: Properties, Fabrication and Application; Koh, K.S., Wong, V.L., Eds.; IntechOpen: Rijecka, Croatia, 2019; pp. 1–18. [Google Scholar]
- Rai, M.; Kon, K.; Gade, A.; Ingle, A.; Nagaonkar, D.; Paralikar, P.; da Silva, S.S. Antibiotic Resistance: Can nanoparticles tackle the problem. In Antibiotic Resistance: Mechanisms and New Antimicrobial Approaches; Kon, K.V., Rai, M., Eds.; Elsevier: Amsterdam, The Netherlands, 2016; pp. 121–143. [Google Scholar]
- Yuvakkumar, R.; Suresh, J.; Nathanael, A.J.; Sundrarajan, M.; Hong, S.I. Novel green synthetic strategy to prepare ZnO nanocrystals using rambutan (Nephelium lappaceum L.) peel extract and its antibacterial applications. Mater. Sci. Eng. C 2014, 41, 7–27. [Google Scholar] [CrossRef]
- Ruddaraju, L.K.; Pammi, S.V.N.; Sankar, G.G.; Padavala, V.S.; Kolapalli, V.R.M. A review on anti-bacterial to combat resistance: From ancient era of plants and metals to present and future perspectives of green nano technological combinations. Asian J. Pharm. Sci. 2019. [Google Scholar] [CrossRef]
- Shaikh, S.; Nazam, N.; Rizvi, S.M.D.; Ahmad, K.; Baig, M.H.; Lee, E.J.; Choi, I. Mechanistic insights into the antimicrobial actions of metallic nanoparticles and their implications for multidrug resistance. Int. J. Mol. Sci. 2019, 20, 2468. [Google Scholar] [CrossRef]
- Raghunath, A.; Perumal, E. Metal oxide nanoparticles as antimicrobial agents: A promise for the future. Int. J. Antimicrob. Agents 2017, 49, 137–152. [Google Scholar] [CrossRef]
- Huh, A.J.; Kwon, Y.J. “Nanoantibiotics”: A new paradigm for treating infectious diseases using nanomaterials in the antibiotics resistant era. J. Control. Release 2011, 156, 128–145. [Google Scholar] [CrossRef]
- Swain, P.; Nayak, S.K.; Sasmal, A.; Behera, T.; Barik, S.K.; Swain, S.K.; Jayasankar, P. Antimicrobial activity of metal based nanoparticles against microbes associated with diseases in aquaculture. World J. Microbiol. Biotechnol. 2014, 30, 2491–2502. [Google Scholar] [CrossRef]
- Raghupathi, K.R.; Koodali, R.T.; Manna, A.C. Size-dependent bacterial growth inhibition and mechanism of antibacterial activity of zinc oxide nanoparticles. Langmuir 2011, 27, 4020–4028. [Google Scholar] [CrossRef] [PubMed]
- Salem, W.; Leitner, D.R.; Zingl, F.G.; Schratter, G.; Prassl, R.; Goessler, W.; Schild, S. Antibacterial activity of silver and zinc nanoparticles against Vibrio cholerae and enterotoxic Escherichia coli. Int. J. Med. Microbiol. 2015, 305, 85–95. [Google Scholar] [CrossRef] [PubMed]
- Fu, L.; Fu, Z. Plectranthus amboinicus leaf extract–assisted biosynthesis of ZnO nanoparticles and their photocatalytic activity. Ceram. Int. 2015, 41, 2492–2496. [Google Scholar] [CrossRef]
- Pati, R.; Mehta, R.K.; Mohanty, S.; Padhi, A.; Sengupta, M.; Vaseeharan, B.; Sonawane, A. Topical application of zinc oxide nanoparticles reduces bacterial skin infection in mice and exhibits antibacterial activity by inducing oxidative stress response and cell membrane disintegration in macrophages. Nanomedicine 2014, 10, 1195–1208. [Google Scholar] [CrossRef]
- Lemire, J.A.; Harrison, J.J.; Turner, R.J. Antimicrobial activity of metals: Mechanisms, molecular targets and applications. Nat. Rev. Microbiol. 2013, 11, 371–384. [Google Scholar] [CrossRef] [PubMed]
- Niño-Martínez, N.; Salas Orozco, M.F.; Martínez-Castañón, G.A.; Torres Méndez, F.; Ruiz, F. Molecular mechanisms of bacterial resistance to metal and metal oxide nanoparticles. Int. J. Mol. Sci. 2019, 20, 2808. [Google Scholar] [CrossRef]
- Shaygannia, E.; Bahmani, M.; Zamanzad, B.; Rafieian-Kopaei, M. A review study on Punica granatum L. J. Evid.-Based Complement. Alternat. Med. 2015, 21, 221–227. [Google Scholar] [CrossRef]
- Kadiyala, U.; Turali-Emre, E.S.; Bahng, J.H.; Kotov, N.A.; VanEpps, J.S. Unexpected insights into antibacterial activity of zinc oxide nanoparticles against methicillin resistant Staphylococcus aureus (MRSA). Nanoscale 2018, 10, 4927–4939. [Google Scholar] [CrossRef]
- Brandelli, A.; Ritter, A.C.; Veras, F.F. Antimicrobial activities of metal nanoparticles. In Metal Nanoparticles in Pharma; Rai, M., Shegokar, R., Eds.; Springer: Cham, Switzerland, 2017; pp. 337–363. [Google Scholar] [CrossRef]
- Dizaj, S.M.; Lotfipour, F.; Barzegar-Jalali, M.; Zarrintan, M.H.; Adibkia, K. Antimicrobial activity of the metals and metal oxide nanoparticles. Mater. Sci. Eng. C 2014, 44, 278–284. [Google Scholar] [CrossRef]
- Saif, S.; Tahir, A.; Chen, Y. Green synthesis of iron nanoparticles and their environmental applications and implications. Nanomaterials 2016, 6, 209. [Google Scholar] [CrossRef]
- Zhu, X.; Pathakoti, K.; Hwang, H.M. Green synthesis of titanium dioxide and zinc oxide nanoparticles and their usage for antimicrobial applications and environmental remediation. In Green Synthesis, Characterization and Applications of Nanoparticles; Ashutosh, K.S., Iravani, S., Eds.; Elsevier: Amsterdam, The Netherlands, 2019; pp. 223–263. [Google Scholar] [CrossRef]
- Ismail, T.; Sestili, P.; Akhtar, S. Pomegranate peel and fruit extracts: A review of potential anti-inflammatory and anti-infective effects. J. Ethnopharmacol. 2012, 143, 397–405. [Google Scholar] [CrossRef] [PubMed]
- Khezerlou, A.; Alizadeh-Sani, M.; Azizi-Lalabadi, M.; Ehsani, A. Nanoparticles and their antimicrobial properties against pathogens including bacteria, fungi, parasites and viruses. Microb. Pathog. 2018, 123, 505–526. [Google Scholar] [CrossRef] [PubMed]
- Moritz, M.; Geszke-Moritz, M. The newest achievements in synthesis, immobilization and practical applications of antibacterial nanoparticles. Chem. Eng. J. 2013, 228, 596–613. [Google Scholar] [CrossRef]
- Tang, Z.X.; Lv, B.F. Magnesium oxide nanoparticles as antibacterial agent: Preparation and activity. Braz. J. Chem. Eng. 2014, 31, 591–601. [Google Scholar] [CrossRef]
- Sorbiun, M.; Shayegan Mehr, E.; Ramazani, A.; Mashhadi Malekzadeh, A. Biosynthesis of metallic nanoparticles using plant extracts and evaluation of their antibacterial properties. Nanochem. Res. 2018, 3, 1–16. [Google Scholar] [CrossRef]
- Aderibigbe, B. Metal-based nanoparticles for the treatment of infectious diseases. Molecules 2017, 22, 1370. [Google Scholar] [CrossRef]
- Shahzad, A.; Saeed, H.; Iqtedar, M.; Hussain, S.Z.; Kaleem, A.; Abdullah, R.; Chaudhary, A. Size-controlled production of silver nanoparticles by Aspergillus fumigatus BTCB10: Likely antibacterial and cytotoxic effects. J. Nanomater. 2019, 1–14. [Google Scholar] [CrossRef]
- Namvar, F.; Rahman, H.S.; Mohamad, R.; Azizi, S.; Tahir, P.M.; Chartrand, M.S.; Yeap, S.K. Cytotoxic effects of biosynthesized zinc oxide nanoparticles on murine cell lines. J. Evid.-Based Complement. Altern. Med. 2015, 1–11. [Google Scholar] [CrossRef]
- Akbar, A.; Sadiq, M.B.; Ali, I.; Muhammad, N.; Rehman, Z.; Khan, M.N.; Anal, A.K. Synthesis and antimicrobial activity of zinc oxide nanoparticles against foodborne pathogens Salmonella typhimurium and Staphylococcus aureus. Biocatal. Agric. Biotechnol. 2018. [Google Scholar] [CrossRef]
- Chaudhary, A.; Kumar, N.; Kumar, R.; Salar, R.K. Antimicrobial activity of zinc oxide nanoparticles synthesized from Aloe vera peel extract. SN Appl. Sci. 2018, 1, 136. [Google Scholar] [CrossRef]
- Rajakumar, G.; Thiruvengadam, M.; Mydhili, G.; Gomathi, T.; Chung, I.M. Green approach for synthesis of zinc oxide nanoparticles from Andrographis paniculata leaf extract and evaluation of their antioxidant, anti-diabetic, and anti-inflammatory activities. Bioprocess Biosyst. Eng. 2017, 41, 21–30. [Google Scholar] [CrossRef]
- Bhuyan, T.; Mishra, K.; Khanuja, M.; Prasad, R.; Varma, A. Biosynthesis of zinc oxide nanoparticles from Azadirachta indica for antibacterial and photocatalytic applications. Mater. Sci. Semicond. Process. 2015, 32, 55–61. [Google Scholar] [CrossRef]
- Umar, H.; Kavaz, D.; Rizaner, N. Biosynthesis of zinc oxide nanoparticles using Albizia lebbeck stem bark, and evaluation of its antimicrobial, antioxidant, and cytotoxic activities on human breast cancer cell lines. Int. J. Nanomed. 2018, 14, 87–100. [Google Scholar] [CrossRef] [PubMed]
- Ashley, E.A.; Lubell, Y.; White, N.J.; Turner, P. Antimicrobial susceptibility of bacterial isolates from community acquired infections in Sub-Saharan Africa and Asian low and middle income countries. Trop. Med. Int. Health 2011, 16, 1167–1179. [Google Scholar] [CrossRef] [PubMed]
- Maxson, T.; Blancett, C.D.; Graham, A.S.; Stefan, C.P.; Minogue, T.D. Rapid antibiotic susceptibility testing from blood culture bottles with species agnostic real-time polymerase chain reaction. PLoS ONE 2018, 13, e0209042. [Google Scholar] [CrossRef]
- Azam, A.; Ahmed, S.A.; Oves, M.; Khan, M.S.; Habib, S.S.; Memic, A. Antimicrobial activity of metal oxide nanoparticles against Gram-positive and Gram-negative bacteria: A comparative study. Int. J. Nanomed. 2012, 7, 6003. [Google Scholar] [CrossRef]
- Khoury, R.A.; Ranasinghe, J.C.; Dikkumbura, A.S.; Hamal, P.; Kumal, R.R.; Karam, T.E.; Smith, H.T.; Haber, L.H. Monitoring the Seed-Mediated Growth of Gold Nanoparticles Using in Situ Second Harmonic Generation and Extinction Spectroscopy. J. Phys. Chem. C 2018, 122, 24400–24406. [Google Scholar] [CrossRef]
- Li, J.; Wu, J.; Zhang, X.; Liu, Y.; Zhou, D.; Sun, H.; Zhang, H.; Yang, B. Controllable synthesis of stable urchin-like gold nanoparticles using hydroquinone to tune the reactivity of gold chloride. J. Phys. Chem. C 2011, 115, 3630–3637. [Google Scholar] [CrossRef]
- Mohammadian, M.; Es’haghi, Z.; Hooshmand, S. Green and chemical synthesis of zinc oxide nanoparticles and size evaluation by UV–vis spectroscopy. J. Nanomed. Res. 2018, 7, 175. [Google Scholar] [CrossRef]
- Goh, E.G.; Xu, X.; McCormick, P.G. Effect of particle size on the UV absorbance of zinc oxide nanoparticles. Scr. Mater. 2014, 78–79, 49–52. [Google Scholar] [CrossRef]
- Ezealisiji, K.M.; Siwe-Noundou, X.; Maduelosi, B.; Nwachukwu, N.; Krause, R.W.M. Green synthesis of zinc oxide nanoparticles using Solanum torvum (L.) leaf extract and evaluation of the toxicological profile of the ZnO nanoparticles–hydrogel composite in Wistar albino rats. Int. Nano Lett. 2019. [Google Scholar] [CrossRef]
- Tensingh, B.N.; Lega, P.S. Biosynthesis and characterization of zinc oxide nanoparticles using onion bulb extract. IJTSRD 2018, 2, 36–44. [Google Scholar] [CrossRef]
- Rajeshkumar, S.; Kumar, S.V.; Ramaiah, A.; Agarwal, H.; Lakshmi, T.; Roopan, S.M. Biosynthesis of zinc oxide nanoparticles using Mangifera indica leaves and evaluation of their antioxidant and cytotoxic properties in lung cancer (A549) cells. Enzyme Microb. Technol. 2018, 117, 91–95. [Google Scholar] [CrossRef] [PubMed]
- Akbarian, M.; Mahjoub, S.; Elahi, S.M.; Zabihi, E.; Tashakkorian, H. Urticadioica leave extracts as a green catalyst for the biosynthesis of zinc oxide nanoparticles: Characterization and cytotoxic effects on fibroblast and MCF-7 cell lines. New J. Chem. 2018, 42, 5822–5833. [Google Scholar] [CrossRef]
- Khatami, M.; Alijani, H.Q.; Heli, H.; Sharifi, I. Rectangular shaped zinc oxide nanoparticles: Green synthesis by stevia and its biomedical efficiency. Ceram. Int. 2018, 44, 15596–15602. [Google Scholar] [CrossRef]
- Umamaheswari, A.; Lakshmana, P.S.; Puratchikody, A. Biosynthesis of zinc oxide nanoparticle: A review on greener approach. MOJ Bioequiv. Bioavailab. 2018, 5, 151–154. [Google Scholar] [CrossRef]
- Azizi, S.; Mohamad, R.; Bahadoran, A.; Bayat, S.; Rahim, R.A.; Ariff, A.; Saad, W.Z. Effect of annealing temperature on antimicrobial and structural properties of bio-synthesized zinc oxide nanoparticles using flower extract of Anchusa italica. J. Photochem. Photobiol. B Biol. 2016, 161, 441–449. [Google Scholar] [CrossRef]
- Murali, M.; Mahendra, C.; Rajashekar, N.; Sudarshana, M.S.; Raveesha, K.A.; Amruthesh, K.N. Antibacterial and antioxidant properties of biosynthesized zinc oxide nanoparticles from Ceropegia candelabrum L.—An endemic species. Spectrochima Acta Part A 2017, 179, 104–109. [Google Scholar] [CrossRef]
- Dhanemozhi, A.C.; Rajeswari, V.; Sathyajothi, S. Green synthesis of zinc oxide nanoparticle using green tea leaf extract for supercapacitor application. Mater. Today 2017, 4, 660–667. [Google Scholar] [CrossRef]
- Wali, M.; Naimat, U.; Muhammad, H.; Bilal, H.A. Optical, morphological and biological analysis of zinc oxide nanoparticles (ZnO NPs) using Papaver somniferum L. RSC Adv. 2019, 9, 29541. [Google Scholar] [CrossRef]
- Ibrahem, E.J.; Thalij, K.M.; Saleh, M.K.; Badawy, A.S. Biosynthesis of zinc oxide nanoparticles and assay of antibacterial activity. Am. J. Biochem. Biotechnol. 2017, 13, 63–69. [Google Scholar] [CrossRef]
- Nazoori, E.; Kariminik, A. In-vitro evaluation of antibacterial properties of zinc oxide nanoparticles on pathogenic prokaryotes. Appl. Biotechnol. Rep. 2018, 5, 162–165. [Google Scholar] [CrossRef]
- Tiwari, V.; Mishra, N.; Gadani, K.; Solanki, P.S.; Shah, N.A.; Tiwari, M. Mechanism of anti-bacterial activity of zinc oxide nanoparticle against Carbapenem-resistant Acinetobacter baumannii. Front. Microbiol. 2018, 9. [Google Scholar] [CrossRef]
- Padmavathy, N.; Vijayaraghavan, R. Enhanced bioactivity of ZnO nanoparticles—An antimicrobial study. Sci. Technol. Adv. Mater. 2008, 9, 35004. [Google Scholar] [CrossRef]
- Liu, Y.; He, L.; Mustapha, A.; Li, H.; Hu, Z.Q.; Lin, M. Antibacterial activities of zinc oxide nanoparticles against Escherichia coli O157:H7. J. Appl. Microbiol. 2009, 107, 1193–1201. [Google Scholar] [CrossRef]
Sample Availability: Samples of the compounds are available from the authors upon request. |

| S/N | Bacteria | Strain Number | Gram Stain |
|---|---|---|---|
| 1 | Staphylococcus aureus | ATCC 25923 | Gram-positive |
| 2 | Streptococcus pneumoniae | ATCC 27336 | Gram-positive |
| 3 | Bacillus cereus | ATCC 10876 | Gram-positive |
| 4 | Enterococcus faecalis | ATCC 29212 | Gram-positive |
| 5 | Listeria monocytogenes | ATCC 19115 | Gram-positive |
| 6 | Enterococcus faecium | ATCC 6569 | Gram-positive |
| 7 | Klebsiella pneumoniae | ATCC 13883 | Gram-negative |
| 8 | Salmonella typhi | Lab isolate | Gram-negative |
| 9 | Escherichia coli | ATCC 25922 | Gram-negative |
| 10 | Pseudomonas aeruginosa | ATCC 27853 | Gram-negative |
| 11 | Moraxella catarrhalis | ATCC 25240 | Gram-negative |
| 12 | Aeromonas hydrophila | ATCC 7966 | Gram-negative |
| 13 | Salmonella diarizonae | ATCC 12325 | Gram-negative |
| S/N | Bacterial Isolates | TET | AMP | AK | GEN | AUG | CIP | NOR | CFX |
|---|---|---|---|---|---|---|---|---|---|
| 1 | Staphylococcus aureus | S | R | S | S | S | S | S | R |
| 2 | Salmonella typhi | NE | NE | S | S | S | S | S | S |
| 3 | Escherichia coli | S | R | S | S | S | S | S | R |
| 4 | Aeromonas hydrophila | S | R | S | S | S | S | S | R |
| 5 | Enterococcus faecalis | S | R | S | S | S | S | S | S |
| 6 | Pseudomonas aeruginosa | NE | NE | S | S | S | S | S | S |
| 7 | Bacillus cereus | S | S | S | S | S | S | S | R |
| 8 | Enterococcus faecium | S | S | S | S | S | R | R | R |
| 9 | Salmonella diarizonae | S | S | S | S | S | S | S | R |
| 10 | Klebsiella pneumoniae | S | R | S | S | S | S | S | R |
| 11 | Moraxella catarrhalis | S | R | S | S | S | S | S | R |
| 12 | Streptococcus pneumoniae | S | S | S | S | S | S | S | R |
| 13 | Listeria monocytogenes | R | S | S | S | S | S | S | R |
| S/N | Bacterial Isolates | 50 µg/mL(mm) | 100 µg/mL(mm) | 1000 µg/mL(mm) | 5000 µg/mL(mm) |
|---|---|---|---|---|---|
| 1 | Staphylococcus aureus | 7.00 ± 1.00 a | 10.50 ± 0.87 a | 11.33 ± 0.58 a | 13.00 a |
| 2 | Salmonella typhi | 6.33 ± 0.58 a | 10.00 a | 11.17 ± 0.29 a | 14.33 ± 0.58 a |
| 3 | Escherichia coli | 13.33 ± 1.15 d | 13.83 ± 0.76 c | 15.00 ± 1.00 b | 15.67 ± 1.53 a |
| 4 | Aeromonas hydrophila | 11.00 ± 2.65 b | 12.33 ± 0.58 a | 13.33 ± 0.58 a | 14.67 ± 1.15 a |
| 5 | Bacillus cereus | 10.33 ± 2.52 b | 13.67 ± 0.58 c | 15.33 ± 0.58 b | 14.33 ± 1.5 a |
| 6 | Listeria monocytogenes | 10.00 ± 1.00 b | 12.00 ± 1.00 a | 12.33 ± 1.15 a | 13.67 ± 1.53 a |
| 7 | Enterococcus faecalis | 6.33 ± 0.29 a | 14.33 ± 0.58 d | 17.33 ± 1.15 d | 18.00 b |
| 8 | Pseudomonas aeruginosa | 9.67 ± 1.53 b | 11.33 ± 0.58 a | 12.67 ± 1.53 a | 15.33 ± 1.53 a |
| 9 | Enterococcus faecium | 12.67 ± 0.58 c | 15.17 ± 0.29 e | 16.67 ± 1.53 c | 19.33 ± 1.15 c |
| 10 | Salmonella diarizonae | 10.83 ± 1.26 b | 12.00 ± 1.73 a | 15.33 ± 1.15 b | 19.00 ± 1.00 c |
| 11 | Klebsiella pneumoniae | 9.67 ± 1.53 b | 11.67 ± 1.53 a | 12.00 ± 1.00 a | 14.00 ± 2.65 a |
| 12 | Moraxella catarrhalis | 8.67 ± 1.15 b | 9.67 ± 1.53 a | 13.33 ± 2.08 a | 14.00 ± 2.65 a |
| 13 | Streptococcus pneumoniae | 10.67 ± 2.31 b | 12.67 ± 0.58 b | 14.67 ± 1.53 a | 16.67 ± 0.58 a |
| S/N | Bacterial Isolates | 50 µg/mL(mm) | 100 µg/mL(mm) | 1000 µg/mL(mm) | 5000 µg/mL(mm) |
|---|---|---|---|---|---|
| 1 | Staphylococcus aureus | 7.00 ± 1.00 a | 12.33 ± 0.58 c | 12.50 ± 0.50 b | 15.00 ± 1.00 a |
| 2 | Salmonella typhi | 5.67 ± 0.58 a | 8.67 ± 1.15 a | 12.00 ± 1.00 a | 14.53 ± 0.23 a |
| 3 | Escherichia coli | 8.67 ± 0.58 c | 10.00 ± 1.00 a | 14.00 ± 1.00 c | 14.50 ± 0.50 a |
| 4 | Aeromonas hydrophila | 10.33 ± 2.05 e | 13.83 ± 0.29 d | 17.33 ± 1.15 g | 17.50 ± 0.50 e |
| 5 | Bacillus cereus | 10.67 ± 2.08 e | 12.33 ± 0.58 c | 14.50 ± 1.32 d | 16.33 ± 0.58 c |
| 6 | Listeria monocytogenes | 6.33 ± 0.58 a | 14.33 ± 0.58 d | 14.67 ± 0.58 e | 16.50 ± 0.50 d |
| 7 | Enterococcus faecalis | 7.33 ± 1.15 a | 9.67 ± 0.58 a | 12.00 ± 1.00 a | 16.17 ± 0.15 c |
| 8 | Pseudomonas aeruginosa | 12.67 ± 0.58 g | 10.00 ± 1.00 a | 13.00 b | 14.00 a |
| 9 | Enterococcus faecium | 9.67 ± 0.58 d | 15.83 ± 0.76 e | 18.00 h | 21.50 ± 0.50 g |
| 10 | Salmonella diarizonae | 10.67 ± 0.58 e | 10.00 a | 16.00 ± 1.00 f | 18.50 ± 0.50 e |
| 11 | Klebsiella pneumoniae | 8.00 ± 1.00 b | 11.00 ± 1.00 b | 10.67 ± 1.15 a | 14.00 a |
| 12 | Moraxella catarrhalis | 12.00 ± 0.50 f | 12.00 ± 1.00 c | 11.67 ± 1.15 a | 15.33 ± 1.44 b |
| 13 | Streptococcus pneumoniae | 10.67 ± 2.30 e | 14.00 ± 1.00 d | 16.00 f | 19.00 ± 0.50 f |
© 2020 by the authors. Licensee MDPI, Basel, Switzerland. This article is an open access article distributed under the terms and conditions of the Creative Commons Attribution (CC BY) license (http://creativecommons.org/licenses/by/4.0/).
Share and Cite
Ifeanyichukwu, U.L.; Fayemi, O.E.; Ateba, C.N. Green Synthesis of Zinc Oxide Nanoparticles from Pomegranate (Punica granatum) Extracts and Characterization of Their Antibacterial Activity. Molecules 2020, 25, 4521. https://doi.org/10.3390/molecules25194521
Ifeanyichukwu UL, Fayemi OE, Ateba CN. Green Synthesis of Zinc Oxide Nanoparticles from Pomegranate (Punica granatum) Extracts and Characterization of Their Antibacterial Activity. Molecules. 2020; 25(19):4521. https://doi.org/10.3390/molecules25194521
Chicago/Turabian StyleIfeanyichukwu, Ugochi Lydia, Omolola Esther Fayemi, and Collins Njie Ateba. 2020. "Green Synthesis of Zinc Oxide Nanoparticles from Pomegranate (Punica granatum) Extracts and Characterization of Their Antibacterial Activity" Molecules 25, no. 19: 4521. https://doi.org/10.3390/molecules25194521
APA StyleIfeanyichukwu, U. L., Fayemi, O. E., & Ateba, C. N. (2020). Green Synthesis of Zinc Oxide Nanoparticles from Pomegranate (Punica granatum) Extracts and Characterization of Their Antibacterial Activity. Molecules, 25(19), 4521. https://doi.org/10.3390/molecules25194521

